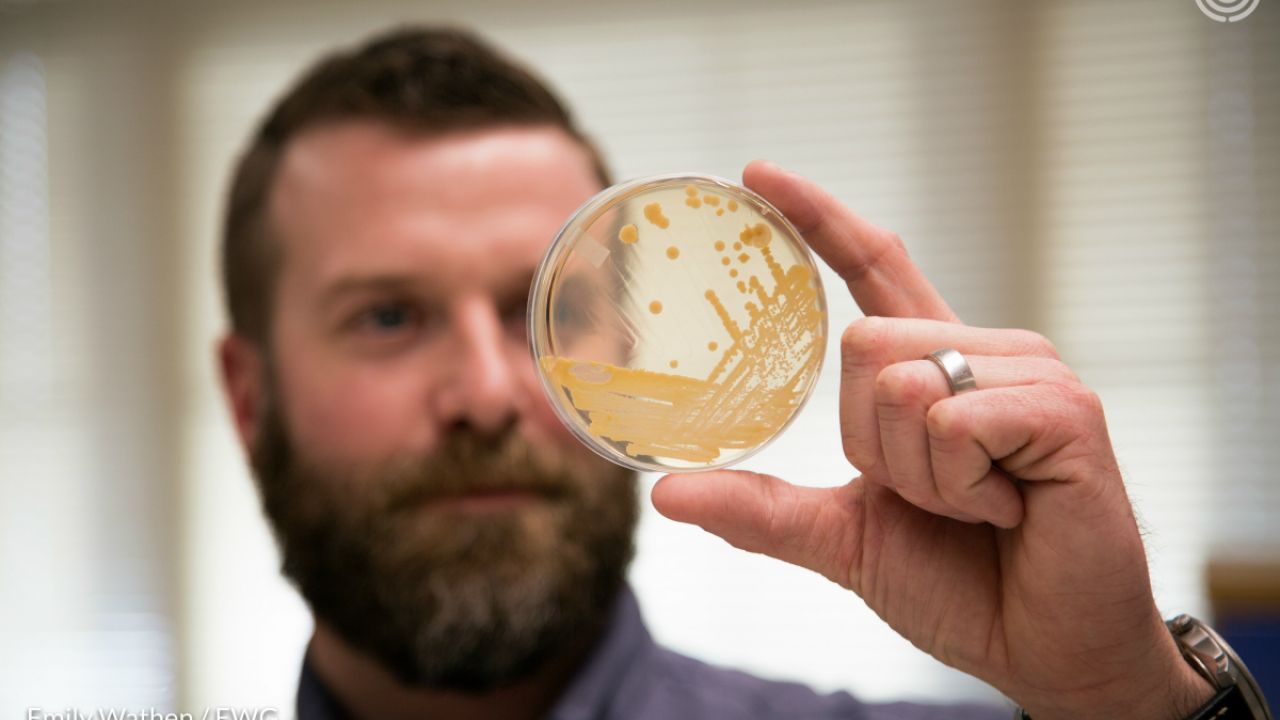

We’re fooling ourselves if we think that voluntary conservation efforts are going to solve the Corn Belt’s dirty water problems.
In fact, “Fooling Ourselves” is the title of a new EWG report that analyzed high-resolution aerial photographs over a four-year period to assess Iowa’s progress – or lack of it – in installing protective vegetation in buffer zones along rivers, streams and grassed waterways atop gullies to reduce agricultural pollution. EWG monitored eight watersheds receiving millions of state dollars to support ineffective voluntary efforts to improve water quality.
When vegetative or grassy cover is installed in and around cultivated fields it helps filter and slow down farm runoff laden with nutrients from fertilizers as well as pesticides and sediment that pollute public water in much of the Midwest.
EWG measured how much of these buffer zones and grassed waterways were installed or removed from 2011 to 2014, and found that there was relatively little positive change to the landscape.
Disappearing Buffer
The survey showed that growers installed 45 acres of buffer zones but plowed up 119 acres, for a net loss of 74 acres within a four year period.

Image from USDA - NAIP (2011) USDA - NAIP (2015)
Vanishing Waterways
During the four years of the study, moreover, EWG’s analysis showed that in areas within farm fields susceptible to the gully erosion from heavy rains, farmers installed 26 miles of grassed waterways but plowed up 21 miles of them, for a net gain of just five miles.

Image from USDA - NAIP (2011) USDA - NAIP (2015)
While many farmers voluntarily introduced these conservation practices, others simply dropped them. U.S. taxpayers, meanwhile, shelled out $1.3 billion to land owners across Iowa to encourage voluntary conservation.
While buffer zones along waterways and grassed waterways within fields won’t solve all agricultural runoff problems, making them a permanent fixture of the landscape would provide a solid foundation for voluntary practices to build on. Establishing permanent conservation standards would give taxpayers more peace of mind, knowing that their dollars won’t go down the drain when the next commodity price boom tempts growers to plow right through protective vegetation.
EWG calls for permanent implementation of these simple but very effective standards:
- Heal or prevent temporary gullies, which are direct pipelines delivering polluted runoff to waterways.
- Keep at least 50 feet of permanent vegetation between cropland and waterways to filter the runoff from farm fields.
- Control the access of livestock to waterways to minimize damage to streams.
- End the application of manure to frozen, snow-covered or saturated ground.
Americans should have more to show for the billions being spent to clean up our water. The time for a basic standard of care is now.
Happily, in some places there has been real progress. Here are a few examples of durable and lasting conservation on the Midwest’s agricultural landscape.
Minnesotans passed a buffer law to protect public water.
Last year, the state passed a buffer law requiring a 50-foot strip of vegetation between cultivated land and public water. The law also offers farmers technical assistance and financial support to establish and maintain buffers, and it strengthens enforcement.
Ohio prohibited spreading manure on saturated or frozen ground.
After repeated algae blooms in Lake Erie threatened Toledo’s drinking water, Ohio took action. In 2015, the legislature passed a law, supported by the Ohio Farm Bureau, which prohibits the application of manure on frozen or snow-covered ground, on rain-saturated soil and whenever heavy rains are forecast.
Wisconsin’s Brown County took steps to keep livestock out of its waterways.
Known for its cheese production and the legendary Green Bay Packers, Brown County has plenty to be proud of. One of its overlooked accomplishments is a progressive shoreland ordinance enacted in the mid-1980s to limit livestock pollution of rivers and streams. The law requires landowners with livestock to fence off “one rod” (16½ feet) along the edge of navigable waterways as a buffer zone. Other provisions maintain livestock’s access to water so long as landowners implement protective conservation measures.
Photo by Emily Wathen. Image of Edward Clark, Laboratory & Wastewater Operations at Des Moines Water Works. He is pictured in the DMWW biology lab.



